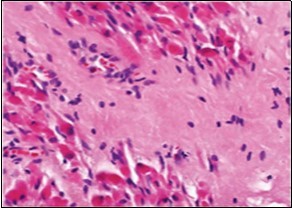

The Bairn’s Blain- Fibromatosis Colli
Abstract
Preface Fibromatosis colli is an exceptional, benign neoplasm of infancy constituted by spindle-shaped cells of sternocleidomastoid muscle. Fibromatosis colli emerges within specific sites such as distal or inferior segment of sternocleidomastoid muscle and is accompanied by diffuse enlargement of the muscle. Although nomenclated as “sternocleidomastoid tumour” or “sternocleidomastoid pseudo-tumour of infancy”, the designation is a misnomer, as the condition is non neoplastic although it may be denominated as a congenital fibrotic disorder.
Author Contributions
Academic Editor: Qiping Dong, China.
Checked for plagiarism: Yes
Review by: Single-blind
Copyright © 2020 Anubha Bajaj
This is an open-access article distributed under the terms of the Creative Commons Attribution License, which permits unrestricted use, distribution, and reproduction in any medium, provided the original author and source are credited.
Competing interests
The authors have declared that no competing interests exist.
Citation:
Preface
Fibromatosis colli is an exceptional, benign neoplasm of infancy constituted by spindle-shaped cells of sternocleidomastoid muscle. Fibromatosis colli emerges within specific sites such as distal or inferior segment of sternocleidomastoid muscle and is accompanied by diffuse enlargement of the muscle. Although nomenclated as “sternocleidomastoid tumour” or “sternocleidomastoid pseudo-tumour of infancy”, the designation is a misnomer, as the condition is non neoplastic although it may be denominated as a congenital fibrotic disorder.
Fibromatosis colli was initially scripted by Hulbert in 1812 as “sternomastoid tumour torticollis “ in German literature 1.
Thereafter, Chandler and Altenberg demonstrated a characteristic, hard, immobile, fusiform swelling within the sternocleidomastoid muscle, usually discerned within two weeks of birth, the magnitude of which enhances for two to four
Subsequent
Weeks until it attains the dimension of a “very large almond” 2. Coined by Hulbert as “tumour torticollis” of sternocleidomastoid muscle, fibromatosis colli is a benign neoplasm associated with congenital fibrosis and manifests a swelling within lateral cervical or supraclavicular region 1.
The neoplasm ensues from fusiform expansion of sternocleidomastoid muscle concomitant with muscle contraction leading to torticollis and cervico- fascial asymmetry. Fibromatosis colli or sternocleidomastoid tumour is a self limiting, fibroblastic lesion accompanied by congenital torticollis and history of birth trauma 3.
Disease Pathogenesis
Of uncertain aetiology, possible birth trauma is suggested as a mechanism of tumour emergence although cogent mechanics with consequent muscle fibrosis remain unexplained. Several theories are posited in the emergence of fibromatosis colli such as foetal malposition, birth trauma, ischemic necrosis following vascular compression during birth, neonatal infection and occurrence of endogenous factors3, 4.
A preferred premise is occurrence of birth trauma or micro trauma of sternocleidomastoid with birth injury engendered from difficult or assisted labour. Pertinent history of a laborious birth is discerned in an estimated 50% instances. Trauma with birth, prolonged difficult labour, breech presentation, forceps delivery and primiparous birth are implicated in genesis of the condition 3, 4.
Another plausible hypothesis is obstruction of venous outflow within the muscle during delivery or intrauterine development. Birth injury engenders necrosis with subsequent fibrosis within muscle fibres, thereby inciting a secondary pressure within the muscle. The tumefaction occurs from an in utero positioning of foetal head which initiates a selective injury to sternocleidomastoid muscle. With pertinent intramuscular injury, development of secondary compartment syndrome with consequent pressure necrosis and fibrosis of the muscle ensues.
Anomalous sternocleidomastoid muscle in association with fibrosis, secondary muscle contracture and manifestations of a compartment syndrome with ischemic lesions occurring due to intrauterine foetal malposition is theorized. Dual mechanism may be interlinked with foetal malposition terminating in laorious delivery 3, 4.
The uncommon condition is discerned in around 0.4% of live births wherein prevalence ranges from 0.3% to 2% and majority of instances are detected prior to six months. However, roughly 50% neoplasms are detected beyond 6 months of neonatal life. A male predilection is observed 3, 4.
An estimated 80% of the benign neoplasm gradually decrease and resolve completely. Concomitant congenital torticollis is documented in around 14% to 20% infants 3,44.
Right sternocleidomastoid muscle is incriminated in an estimated 60% to 75% instances whereas bilateral tumour occurrence is delineated in around 22% subjects 3, 4.
Clinical Elucidation
Fibromatosis colli is accompanied by a characteristic clinical history and representation. Infant typically manifests a smooth, fusiform mass within the distal or inferior one third of sternocleidomastoid muscle and stiff neck with restricted neck mobility. Clinically, a lateral cervical swelling occurring within first month of life is indicative of fibromatosis colli.
As the tumefaction is generally incorporated within distal one third of sternocleidomastoid muscle, the mobile mass can be palpated beneath superimposed cutaneous surface 5, 6.
Fibromatosis colli typically demonstrates an intramuscular mass within one week to eight weeks which is accompanied by torticollis and a non tender, firm, fusiform swelling within the body of sternocleidomastoid muscle 5, 6.
Fibromatosis colli is generally absent at birth and discerned between 2 weeks to 4 weeks of neonatal life although majority of tumefaction are detected prior to six months. Mean age of disease representation is twenty four days Classically, a palpable, solid tumefaction is observed within anterior neck segment superimposed upon the sternocleidomastoid muscle. Lateral cervical tumefaction induces a reduced lateral mobility of the head within first few weeks 5, 6. The intramuscular mass demonstrates an initial growth phase and can increase for several weeks followed by a phase of stabilization, which lasts for a few months and finally retrogresses spontaneously within four months to eight months 6.
Fibromatosis colli can be associated with congenital defects, particularly congenital muscular disorders as club foot or congenital dislocation of hip 3, 4. Tumour nodule is devoid of additional clinical anomalies. Although fibromatosis colli can induce respiratory failure and may necessitate a subsequent tracheostomy, the complication remains undocumented 4.
Histological Elucidation
On gross examination, a tan coloured, gritty nodule, confined to the sternocleidomastoid muscle is delineated. Characteristically, smears obtained by fine needle aspiration cytology are composed of bland appearing, plump or normal fibroblasts and proliferating fibroblasts with an admixture of degenerative, atrophic skeletal muscle cells, giant myocytes with several nuclei, scattered, bare, bland nuclei or cells with fragmented, wispy cytoplasm and parallel aggregates of fibroblasts. The background is clear and devoid of cellular or nuclear debris. Sheets of spindle-shaped fibroblasts, atrophic muscle fibres and regenerating, multinucleated muscle giant cells are intermingled with the fibroblastic component 5, 6.
On microscopy, a collagen- rich, minimally cellular, fibrotic soft tissue nodule is exemplified which simulates a scar or conventional fibroma. The neoplasm is comprised of uniform, plump, fibroblastic or myo-fibroblastic cells encompassed in a collagen-rich stroma with infiltration and entrapment of skeletal myocytes 5, 6. Cogent histological examination depicts replacement of muscle fibres and muscle mass with fascicles of fibrous tissue comprised of mature fibroblastic cells, thereby conferring fibrosis 6. Figure 1, Figure 2, Figure 3, Figure 4, Figure 5, Figure 6, Figure 7, Figure 8.
Figure 1.Fibromatosis colli depicting bundles of fibroblasts and myo-fibroblasts intermixed with a collagenous stroma and entrapped myocytes 9.
Figure 2.Fibromatosis colli demonstrating fascicles of fibroblasts and myo-fibroblasts within an abundant collagenous stroma and several mature myocytes 10.
Figure 3.Fibromatosis colli depicting fascicles of fibroblasts and myo-fibroblasts admixed with a collagenous stroma and extravasation of numerous red blood cells 10.
Figure 4.Fine needle aspiration cytology of fibromatosis colli delineating aggregates of plump, spindle-shaped cells admixed with fibroblasts, fibro-connective tissue fragments and intermingled red cell extravasation 11
Figure 5.Fine needle aspiration cytology of fibromatosis colli exhibiting aggregates of spindle- shaped cells, plump fibroblasts, fibro-connective tissue fragments and a clear background with minimal red cell extravasation 12.
Figure 6.Fibromatosis colli depicting clusters of spindle-shaped cells, plump fibroblasts and comingled mature skeletal muscle fibres with collagen-rich stroma 13.
Figure 7.Fibromatosis colli exhibiting fibroblasts, myo-fibroblasts and an abundant collagenous stroma with commixture of enlarged myocytes 14.
Figure 8.Fibromatosis colli enunciating fibroblasts, myo-fibroblasts and collagenous stroma with dispersed mature myocytes 14.
Differential Diagnosis
Fibromatosis colli requires a segregation from cogent congenital conditions such as enlarged cervical lymph nodes (possibly reactive with follicular hyperplasia), cervical abscess, bronchogenic cyst, dislocation of thyroid lobe, branchial cyst, thyroglossal duct cyst, inflammatory disorders as granulomatous, tubercular lymphadenitis. Neoplastic conditions as the benign haemangioma or cystic hygroma besides malignant neoplasia as neuroblastoma, rhabdomyosarcoma, lymphoma, teratoma and fibrosarcoma also necessitate a demarcation 3, 4.
Vascular and lymphatic malformations such as haemangioma or lymphangioma mandate evaluation besides bronchogenic cyst and thyroglossal duct cyst. Neck abscess is infrequent in neonates although can be discerned in older children or when accompanied by immunodeficiency3, 4.
Investigative Assay
On radiographic imaging, a uniform, isoechoic mass is detected, confined to the muscle. Fine needle aspiration cytology (FNAC) can be successfully adopted for diagnostic confirmation and segregation from associated congenital, inflammatory or neoplastic disorders, emerging at identical sites and within identical age group. The procedure is contemplated as a first line investigative modality for detecting infantile fibromatosis colli. It is a rapid, cost-effective, reliable procedure which can appropriately exclude adjunctive, benign or malignant supraclavicular or cervical nodules3, 4.
Extensive clinical examination can satisfactorily diagnose the condition. Ultrasonography is a preferential diagnostic tool on account of accessibility, cost effectiveness and lack of exposure to ionizing radiation. A competent ultrasound is beneficial and can eliminate associated aetiologies in instances where clinical aspect is atypical 7. Ultrasonography delineates factors associated with congenital torticollis and lateral, cervical masses besides monitoring tumour development 7. Ultrasound scan of congenital fibromatosis colli typically displays a fusiform thickening of sternocleidomastoid muscle. Characteristically, fibromatosis colli demonstrates a fusiform or diffuse enlargement of sternocleidomastoid muscle with consequent muscle shortening and head tilting towards the opposite side.
Tumour echogenicity is variable. Colour Doppler can display an enhanced resistance waveform7. Computerized tomography (CT) and magnetic resonance imaging (MRI) are advantageous in discerning the neoplasm and enunciate thickening of sternocleidomastoid muscle. Cross sectional computerized tomography (CT) or magnetic resonance imaging (MRI) can be occasionally employed to eliminate adjunctive conditions, especially with equivocal or atypical clinical features. Also, the modalities are beneficial for further characterization of disease and assessing extent of muscular involvement7, 8.
Computerized tomography (CT) typically demonstrates an enlarged sternocleidomastoid muscle which is iso-attenuating from normal, neighbouring musculature. Planes of adjacent adipose tissue are preserved. Calcification may be detected 8.
Magnetic resonance imaging (MRI) displays a well defined mass with an enhanced signal intensity upon T1 weighted and T2 weighted imaging circumscribed by tissue with normal signal intensity and muscle 8.
Therapeutic Options
In the absence of adequate treatment, spontaneous retrogression of the neoplasm can ensue in 4 months or 6 months which can be facilitated or accelerated by appropriate physiotherapy. Surgical treatment is infrequent and adopted in beneath < 5% instances with antecedent diagnosis 7, 8. Preliminarily discerned tumefaction can be appropriately managed with non surgical techniques. Conservative management can be suitably adopted, contingent to appropriate diagnosis, thus circumventing superfluous surgical intervention 7, 8.
Majority (90%) of instances are suitably alleviated with conservative management. Cogent therapies comprise of passive stretching of incriminated muscle and physiotherapy. An estimated 70% infants demonstrate complete resolution of the mass with normal cervico-fascial posture and mobility 7, 8.
Surgical intervention is beneficial in around 10% to 15% instances, especially in refractory neoplasms or incriminated children exceeding > one year, wherein tenotomy or tenomyotomy is a principally adopted procedure. Delayed diagnosis and therapeutic intervention, when occurring in children beyond > one year, is accompanied by inferior outcomes 7, 8.
References
- 3.Valentino K, Tothy A S. (2020) Fibromatosis Colli- a case report”. , Adv Emerg Nurs J 42(1), 13-16.
- 4.Adamoli P, Pavone P. (2014) Rapid spontaneous resolution of Fibromatosis Colli in a 3-week old girl. Case Rep Otolaryngol.264940.
- 5.Chao M, Pegbessou P E. (2015) Congenital Fibromatosis Colli or torticollis- it’s diagnosis and management in two cases. , Pan Afr Med J 22, 74.
- 6.Smith A, Cronin M. (2019) Paediatric neck lumps- An approach for the primary physician”. , Australian Journal of General Practice 48(5), 289-93.
Cited by (4)
This article has been cited by 4 scholarly works according to:
Citing Articles:
Hatice Buket Özay, Ayşe Füsun Bekirçavuşoğlu, Müjgan Arslan - Pediatric Academic Case Reports (2025) Semantic Scholar
J. Houas, Safa Jamli, Heyfa Belhadj-Miled, M. Ghammam, M. Abdelkefi - Medical Reports (2024) Semantic Scholar
